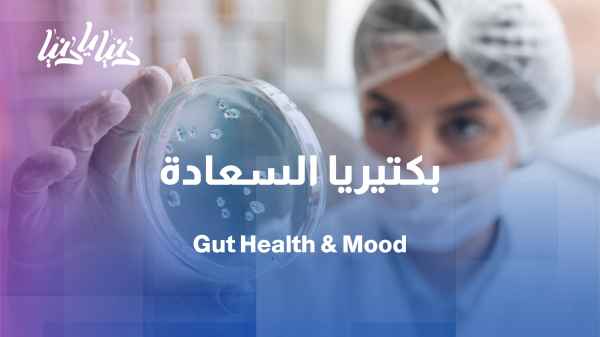

Loading video
How do beneficial bacteria affect anxiety and depression?
duration: 09:41
From the gut to mood… how do beneficial bacteria change our psychological state?

Migraines on the table: What to eat and what to avoid?
duration: 08:28
Foods under scrutiny: What triggers migraines?

Attar Pharmacy: Between herbs and hormones, who is responsible for increased milk production?
duration: 10:26
The herbalist's pharmacy: Herbs that increase milk production... what actually works?

How can we identify foods that cause bloating and stomach sensitivity?
duration: 09:16
What foods cause bloating? And how can we detect them?

How to prepare healthy nuggets at home in simple steps - Light Bites with Ruba Masharbash
duration: 08:35
How to prepare healthy nuggets at home in simple steps - Light Bites with Ruba Masharbash

The herbalist's pharmacy: Relaxation begins with simple herbs.
duration: 09:04
Attar Pharmacy: The secrets to deep sleep begin in your kitchen

From anxiety to relaxation: A menu to help you sleep and calm down
duration: 05:17
No more insomnia: Natural foods that help you relax before bed
















